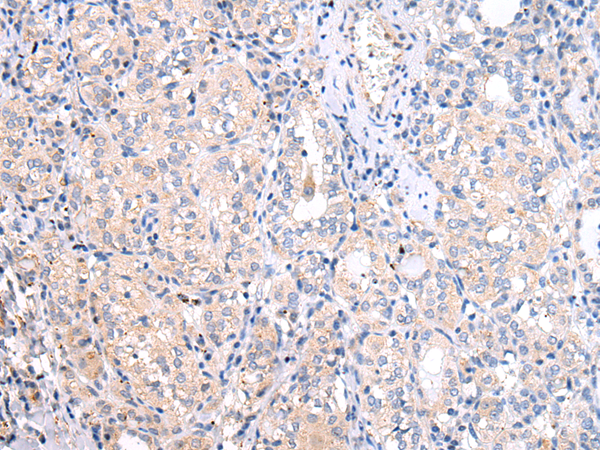

中文名稱:兔抗ATF6多克隆抗體
|
Background: |
This gene encodes a transcription factor that activates target genes for the unfolded protein response (UPR) during endoplasmic reticulum (ER) stress. Although it is a transcription factor, this protein is unusual in that it is synthesized as a transmembrane protein that is embedded in the ER. It functions as an ER stress sensor/transducer, and following ER stress-induced proteolysis, it functions as a nuclear transcription factor via a cis-acting ER stress response element (ERSE) that is present in the promoters of genes encoding ER chaperones. This protein has been identified as a survival factor for quiescent but not proliferative squamous carcinoma cells. There have been conflicting reports about the association of polymorphisms in this gene with diabetes in different populations, but another polymorphism has been associated with increased plasma cholesterol levels. This gene is also thought to be a potential therapeutic target for cystic fibrosis. |
|
Applications: |
ELISA, WB, IHC |
|
Name of antibody: |
ATF6 |
|
Immunogen: |
Synthetic peptide of human ATF6 |
|
Full name: |
activating transcription factor 6 |
|
Synonyms: |
ATF6A |
|
SwissProt: |
P18850 |
|
IHC positive control: |
Human thyroid cancer and human breast cancer |
|
IHC Recommend dilution: |
10-50 |
|
WB Predicted band size: |
75 kDa |
|
WB Positive control: |
Hela cell lysate |
|
WB Recommended dilution: |
200-1000 |

購物車
幫助
021-54845833/15800441009
